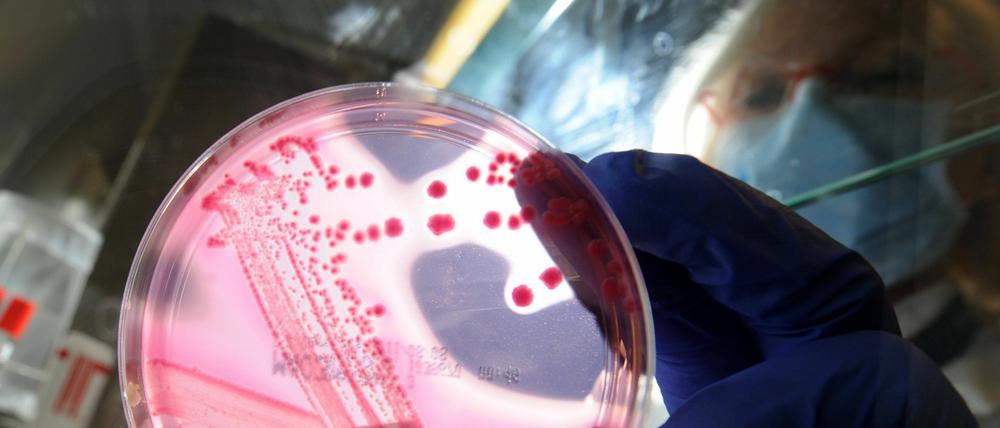

© dpa
EHEC: Warnung vor Salat, Gurken und Tomaten aus Norddeutschland
Nach dem EHEC-Ausbruch arbeiten die Forscher unter Hochdruck. "E.coli O104" soll Ursache der Infektionen sein - ein sehr seltener Erreger. Nun gibt das Robert-Koch-Institut eine erste Warnung heraus.
Stand:
Seit der zweiten Maiwoche sind vermehrt Personen an blutigem Durchfall und dem so genannten hämolytisch-urämischen Syndrom (HUS) erkrankt. Die Fälle traten vor allem in Norddeutschland auf, es gibt aber auch vorläufige Meldungen aus Süd- und Ostdeutschland. Dem Robert-Koch-Institut (RKI) wurden bis zum Dienstagabend rund 140 HUS-Fälle übermittelt, darunter drei Todesfälle. Die Zahl der schweren Verläufe in einem kurzen Zeitraum ist sehr ungewöhnlich, auch die betroffenen Altersgruppen sind untypisch. Aktuell sind vor allem Erwachsene, überwiegend Frauen, betroffen.
Das Robert Koch-Institut warnt nun davor, rohe Tomaten, Salatgurken und Blattsalate aus Norddeutschland zu essen. Die EHEC-Erkrankten in einer Studie hätten diese Gemüse deutlich häufiger gegessen als gesunde Vergleichspersonen, teilte das Institut am Mittwoch in Berlin mit.
Der EHEC-Erreger, der zurzeit in Deutschland grassiert, gehört offenbar zu einem seltenen Stamm. Das haben erste Untersuchungen des Nationalen Referenzlabors für EHEC-Infektionen in Wernigerode ergeben. In den Stuhlproben von fünf Patienten seien EHEC-Erreger vom Typ O104 gefunden worden, sagte Klaus Stark, Arbeitsgruppenleiter für gastrointestinale Infektionen und Zoonosen am RKI dem Tagesspiegel. Er hoffe, dass im Laufe des Tages weitere Proben klar identifiziert werden könnten. "Aber im Moment deutet alles darauf hin, dass ein E.coli O104 Ursache der Infektionen ist."
Dieser E.coli-Typ gehört nicht zur "Fünferbande" von EHEC, die in Europa die meisten Erkrankungen verursachen. "Dieser Erreger ist äußerst selten", sagte Helge Karch, Leiter des Konsiliarlabors für hämolytisch-urämisches Syndrom (HUS) an der Universität Münster. "In unserer Sammlung von 588 EHEC-Isolaten, die wir über 20 Jahre von HUS-Patienten gesammelt haben, taucht O104 nur zweimal auf." Er könne noch nicht bestätigen, dass O104 wirklich der Erreger sei, sagte Karch. "Es handelt sich bei diesem Ausbruch aber in jedem Fall um einen sehr seltenen Erreger." Das hätten Tests in seinem Labor ebenfalls gezeigt.
Lothar Beutin, EHEC-Experte am Bundesinstitut für Risikobewertung glaubt, dass der seltene Erreger, die Suche nach der Infektionsquelle zunächst erschweren könnte. "E.coli O104 ist sehr schwer von normalen E.coli-Bakterien zu unterscheiden", sagte er. Es gelte jetzt, möglichst schnell einen guten Test für das Bakterium zu entwickeln. Sollte das aber gelingen, könnte es die Untersuchung des EHEC-Ausbruches sogar erleichtern. Denn der seltene Erreger bedeutet auch, dass Ärzte gut unterscheiden können, welche Fälle zu dem aktuellen Ausbruch gehören und auf eine gemeinsame Quelle zurückzuführen sind und welche nur zufällig zur gleichen Zeit auftreten. Die Infektionsquelle ist nach wie vor ungewiss.
E.coli O104 fiel erstmals 1994 als Krankheitserreger auf. Damals erkrankten im Februar und März mehrere Menschen in Helena, Montana. Sie litten unter schweren Magenkrämpfen und blutigem Durchfall, vier von ihnen kamen ins Krankenhaus. Eine Untersuchung der amerikanischen Seuchenschutzbehörde CDC ergab später, dass E.coli O104:H21 die Ursache der Erkrankung war. Als Quelle der Infektion vermuteten die Seuchenexperten Milch. Fast alle Erkrankten tranken zu Hause Milch der selben Marke. Der Erreger konnte aber weder in der Molkerei noch bei den Kühen nachgewiesen werden. Interessanterweise waren in Montana, ähnlich wie jetzt in Deutschland, mehr Erwachsene als Kinder und mehr Frauen als Männer betroffen.
- showPaywall:
- false
- isSubscriber:
- false
- isPaid: